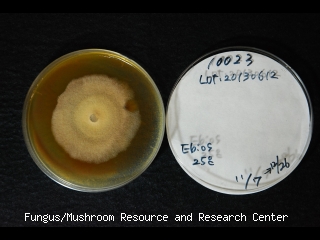

Taxonomic information
- TUFC No.
- 10023
- Division
- Basidiomycota
- Class
- Agaricomycetes
- Subclass
- Agaricomycetidae
- Order
- Boletales
- Fungus Name
- Rhizopogon roseolus (Corda) Th. Fr.
- Reception Name
- Rhizopogon roseolus
Information of deposit, history of strain et al.
- Date of deposit
- 2005/04/01
- Registered by
- N. Maekawa
- Affiliation
- TMI
- History
- <- N. Shimomura (TMI, RR501)
- Other Strain no.
- RR501
Information of collector, source et al.
- Date
- 2005/11/25
- Source of isolation
- Basidioma
- Isolation method
- Tissue isolation
Collected location
- Habitat
- On pine tree
- Scientific name of source
- Pinus thunbergii
- Locality
- Experimental Forestry Station, Yasuhara, Kanazawa-shi, Ishikawa Pref., Japan
Information of voucher specimen
Photo(s)
Sequence information
- Sequenced region 1
- ITS1-ITS2
- Sequence Data 1
- >D10023_its_20160303_AE ATAATTCGGAGGGGCTGTAGCTGGCCTTGGAACGAGGCATGTGCACGCTCTTCCGTTTTTCACAAACTCACCTGTGCACC TAATGTAGGATGCTCCTCTTTCGGGAGGGGGGGACCTATGTCTTCATATACCACTTCGTGTAGAAAGTCTTAGAATGTTT TACTATCGGAGAGTCGCGACTTCTAGGAGACGCGAATCTACGAGATAAAAGTTAATTACAACTTTCAGCAATGGATCTCT TGGCTCTCGCATCGATGAAGAACGCAGCGAAAAGCGATATGTAATGTGAATTGCAGATCTACAGTGAATCATCGAATCTT TGAACGCACCTTGCGCTCCTCGGTGTTCCGAGGAGCATGCCTGTTTGAGTGTCAGTAAATTCTCAACCCCTCTCGATTTG TTTCGAGGGGGAGCTTGGATGGTGGGGGCTGCCGGAGACTAGGACTCGTCCTGGACTCGGGCTCTCCTTAAATGCATCGG CTTGCGGTCGACTTTCGACTTTGCGCGACAAGGCTTTCGGCGTGATAATGATCGCCGTTCGCTGAAGCGCATGAATGAAG GTCCCGCGCCTCTAATACGTCGACTGTTACTATCTCTTCGGAGAGAAAACGTC
Unauthorized copying and replication of the contents of this site, text and images are strictly prohibited.
Reference(s)
Additional information
- Biosafety level
- L1
- Physical containment
- P1
- Medium
- MA
- Incubation temp.
- 25 ℃
- Date of released
- 2013/05/01
- Date of last modified
- 2022/03/11